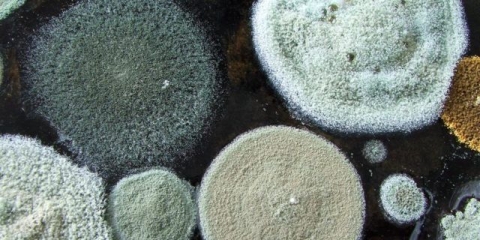
Mliječne gljive su pljesnive: šta učiniti s njima, zašto se pojavljuje plijesan, kako je izbjeći

Kako čuvati gljive nakon soljenja kod kuće
Istinski ljubitelji gljiva među raznovrsnim darovima prirode ističu gljive. Ove gljive po ukusu spadaju u prvu kategoriju. Stoga se mnoge domaćice trude da od njih naprave kisele krastavce za buduću upotrebu kako bi zimi uživale u ukusnoj poslastici. Da biste to učinili, svakako morate znati kako pravilno skladištiti slane gljive. Pod potrebnim uslovima skladištenja, slane pečurke mogu dugo ostati ukusne i zdrave.

Šta određuje rok trajanja slanih gljiva
Preporučljivo je jesti svježe gljive u roku od jednog dana nakon što su sakupljene. Ne čuvajte nekuvane pečurke. Brzo se pokvare. Ako ih nije moguće odmah skuhati na ovaj ili onaj način, onda ih treba očistiti od ostataka i držati u frižideru ne više od jednog dana. Nema potrebe za pranjem vodom. Zatim ih treba skuvati ili baciti.
Za dugotrajno skladištenje, gljive se mogu kiseliti, sušiti, zamrznuti i, naravno, soliti. Postoje faktori na koje morate obratiti pažnju kada pripremate slane mliječne kapice od šafrana za čuvanje kod kuće. Oni utiču na kvalitet soljenja i rok trajanja hrane.
Postoji nekoliko takvih faktora:
- Temperatura vazduha u kojoj se nalazi so. Mora biti najmanje 00C, tako da se slane pečurke ne smrznu, a ne više od +70C da se ne pokvare.
- Nedostatak svjetla. Mjesto za skladištenje treba ostati tamno većinu dana, posebno treba isključiti direktnu sunčevu svjetlost.
- Metoda soljenja. Može biti sa ili bez prethodno skuvanih pečuraka.
- Takođe je potrebno staviti dovoljnu količinu konzervansa (soli), što u velikoj meri utiče na vreme skladištenja. Koliko soli treba staviti zavisi od uslova skladištenja. Kada postoji hladan podrum, tada iskusne domaćice stavljaju manje soli nego u nedostatku takvog mjesta za skladištenje.
- Kontejneri za skladištenje radnih komada. Možete koristiti stakleno, drveno, emajlirano posuđe ili druge neoksidirajuće posude. Sterilizirane staklene tegle su najbolja opcija za čuvanje slanih gljiva što je duže moguće.
Svo vrijeme skladištenja mora biti praćeno slanom vodom. Ako ostane proziran ili blago zamućen, poprimio je smećkastu nijansu, onda sve ide kako treba. U slučaju kada je salamura pocrnila, kiseljenje se mora baciti, jer je postalo neprikladno za ljudsku ishranu.
Kako čuvati slane pečurke
Na rokove i uslove skladištenja gljiva nakon soljenja u velikoj meri utiče način berbe. Postoje 2 glavne opcije:
- Vruće - pečurke se kuvaju pre soljenja. Nakon hlađenja stavljaju se u tegle i posipaju solju. Za kiseljenje, radni komad se mora držati u frižideru 6 nedelja. Istovremeno, zbog termičke obrade gube se neka od korisnih svojstava, ali se smanjuje rizik od brzog propadanja i zadržava izgled.
- Hladno - pečurke se sole sirove bez prethodne termičke obrade. Stavljaju se u posudu, posipaju solju. Na vrh se postavlja ravan predmet i na njega se stavlja uteg da ga pritisne. Izdržati 2 sedmice na temperaturi od +10…+150WITH. Zatim stavite u frižider na 1,5 mesec. Proces soljenja na ovaj način traje 2 mjeseca. Istovremeno, većina korisnih i ukusnih kvaliteta je očuvana, ali postoji vjerojatnost plijesni ako se ne poštuju uvjeti skladištenja. Boja samih gljiva lagano se mijenja, postaje tamnija.
Ni u jednom jelu ne možete soliti pečurke. Odabir posuđa u kojem će se čuvati ukiseljene gljive utječe na rok trajanja proizvoda. Slane gljive možete jesti tek nakon završetka faze soljenja, ali ne prije.

Kako čuvati slane pečurke nakon soljenja
Ako se šampinjoni posole bez prethodnog kuhanja i stave u drvenu bačvu ili emajliran tiganj, onda se gljive nakon takvog hladnog soljenja mogu čuvati oko 6-8 mjeseci. pod uslovom da temperatura ne prelazi +6…+80WITH.
U tom slučaju također morate redovno čistiti gazu i ugnjetavanje od formirane plijesni i paziti da salamura prekriva gljive. Ako salamura ne pokrije u potpunosti slane gljive, potrebno je dodati hladnu prokuhanu vodu.
Kako čuvati slane pečurke u teglama
Toplo kuvani kiseli krastavci čuvaju se u teglama. Da bi se duže čuvali u teglama, konzerviranje treba obaviti na sljedeći način:
- Očistite pečurke od šumskih ostataka i dobro isperite sa dosta hladne vode.
- Kuvajte u slanoj vodi 7-10 minuta.
- Ocijedite vodu, ostavite da se potpuno ocijedi.
- Ređati u tegle u slojevima, posuti solju i začinima.
- Prelijte kipućom vodom i zatvorite kapron poklopcima.
- Nakon hlađenja odnijeti na hladno mjesto za dugotrajno čuvanje.
Takve praznine treba čuvati u prostoriji s temperaturom ne višom od +80WITH. Tada će slane pečurke biti jestive 2-3 mjeseca. Ako tegle zamotate metalnim poklopcima, onda će uz pravilno skladištenje kiseli krastavci ostati jestivi još 2 godine.
Postoje mali trikovi koji pomažu da slane gljive budu jestive cijelu zimu. Jedna od njih je upotreba biljnog ulja. Nakon što su pečurke spakovane u tegle i napunjene salamurinom, na vrh se prelije biljno ulje tako da njegov sloj pokrije površinu salamure i bude debljine oko 5 mm. Ova tehnika sprječava stvaranje plijesni na površini salamure i produžava skladištenje.
Na kojoj temperaturi čuvati slane pečurke
Slane pečurke već pripremljene za dugotrajno skladištenje treba čuvati u prostoriji sa optimalnom temperaturom za to - od 0 do +80WITH. Podrum ili podrum su dobri za skladištenje. Ako nema takvih opcija, tada se posude s kiselim krastavcima mogu staviti na donju policu hladnjaka. U slučaju kada nema dovoljno prostora u frižideru, možete koristiti izoliranu lođu, ali pazite da temperatura bude u prihvatljivim granicama.
Koliko dugo se čuvaju soljene pečurke
Vruće soljene i hermetički zatvorene u teglama, pečurke se čuvaju u odgovarajućim uslovima oko 24 meseca. Za to vrijeme treba ih jesti. Kiseli krastavci zatvoreni najlonskim poklopcima treba da budu u frižideru. U tom slučaju ostaju jestivi 2 mjeseca. nakon soljenja.
Hladno soljene pečurke će biti jestive šest meseci ako se čuvaju u frižideru ili hladnoj prostoriji.
Otvorene tegle sa kiselim krastavcima mogu se držati na donjoj polici frižidera do 2 nedelje. Ako za to vrijeme delicija nije pojedena, bolje je baciti je kako ne biste riskirali svoje zdravlje.
Zaključak
Da biste zimi mogli probati svoje omiljene gljive, ako želite, morate znati kako skladištiti slane pečurke po svim pravilima. Nema ništa komplikovano u tome. Neophodno je obezbediti blanko potrebnu temperaturu skladištenja i pratiti njihovo stanje po izgledu i mirisu. Na prvi znak kvarenja, bolje je riješiti se sumnjivih slanih gljiva nego riskirati svoje zdravlje.